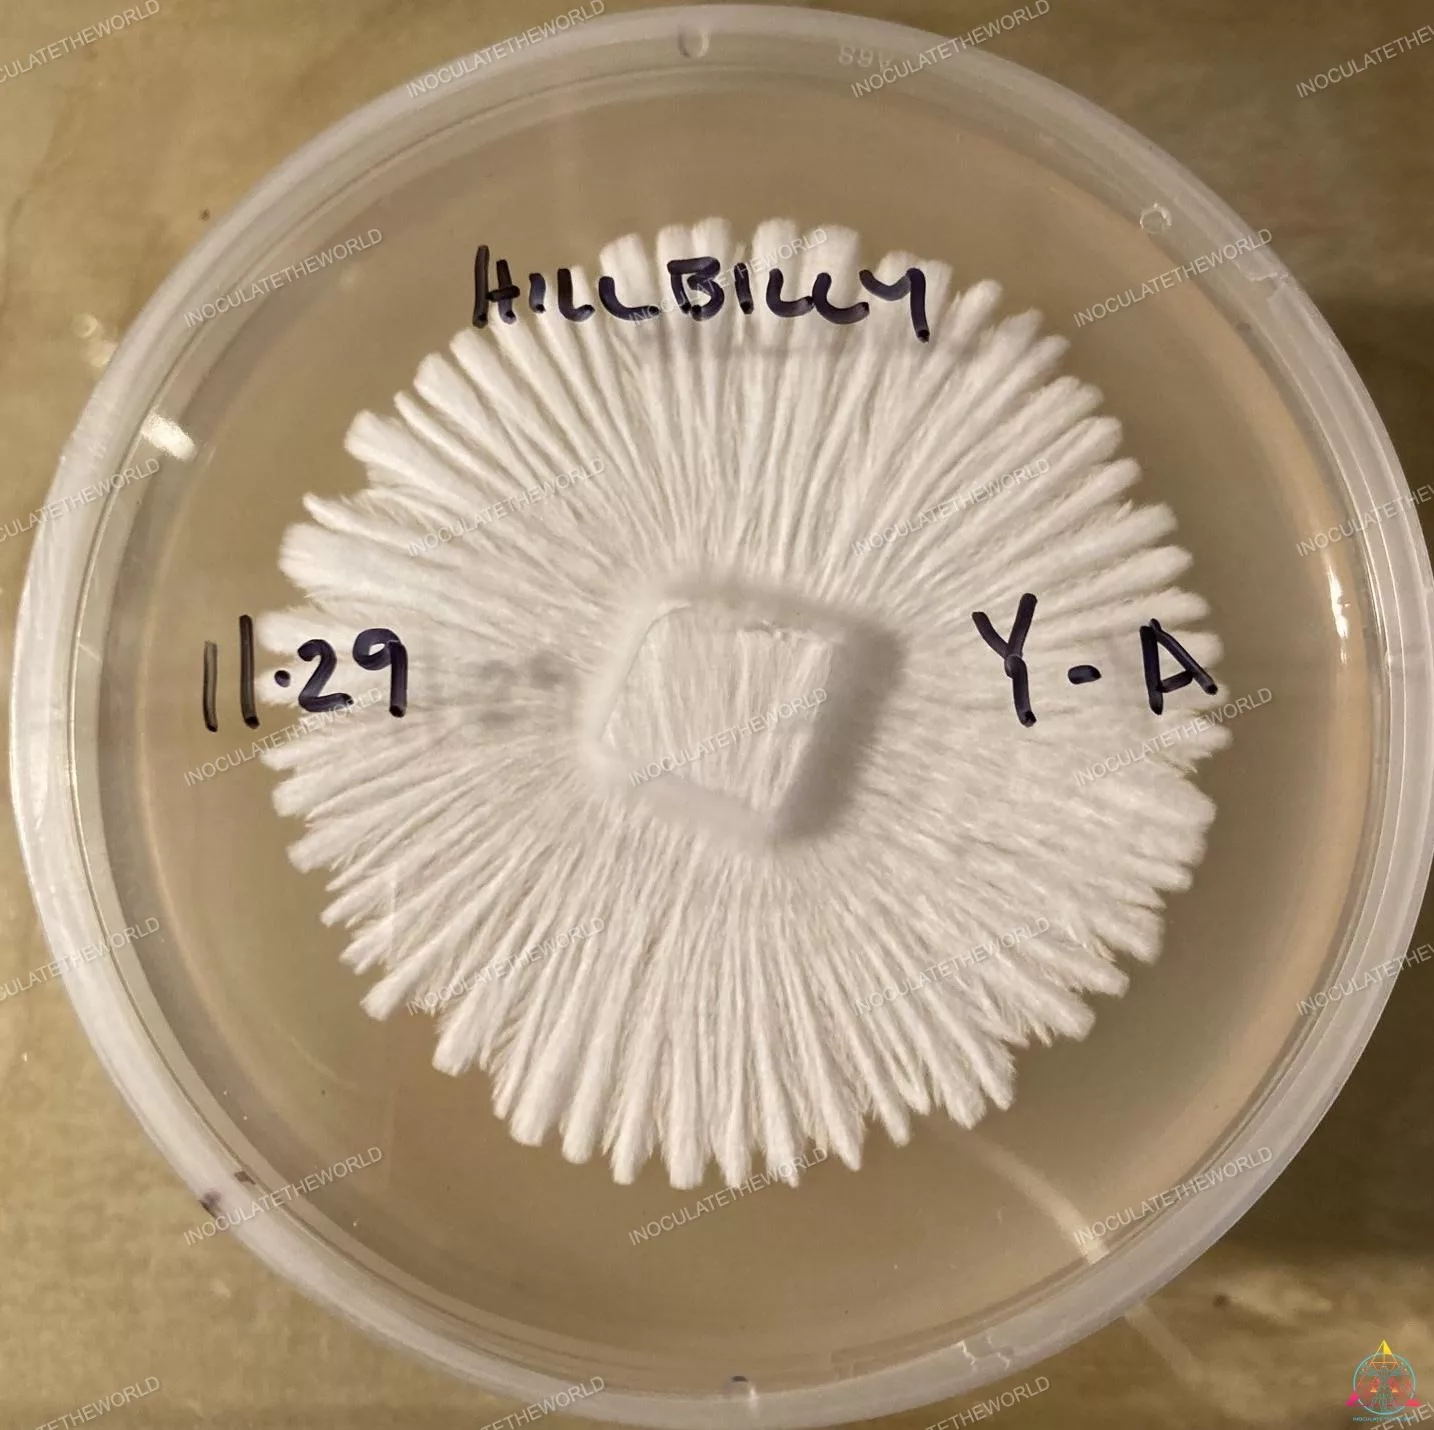
Hillbilly Cubensis Isolated Spore Syringe - Image 6

Description
Hillbilly cubensis came to the scene to make a statement, and that it did. This heavily isolated Psilocybe cubensis strain has taken to the genetics community like a storm, spreading its mycelium far and wide across the globe. The Hillbilly mushroom strain comes from an Arkansas cubensis, named by a mycotopia user who went by the username Hillbilly.
This strain is one of the fastest colonizers we have seen. It throws rhizo ropes reminiscent of the one-of-a-kind Golden Halo. Growers in Amsterdam and Jamaica say Hillbilly cubensis produces consistent full flushes of thick stemmed, almost solid fruits with high potency. The Hillbilly strain is a must have, and is now available in its peak isolated form. This strain will be of great interest to commercial cultivators.
Our Hillbilly Cubensis spore syringes all use 12cc luer-lok syringes and include one 1.5in 16ga needle. InoculateTheWorld spore syringes are always backed by a guarantee for clean and viable magic mushroom spores, and the highest quality, well-curated genetics.

rbrian.sullivan –
Could not be more pleased with these genetics! Thanks ITW!!!
kagaencomputers –
3 days is all it took Mycelium everywhere 16 days it’s now ready to go and I expect this will be a fast grower as well I’m guessing at day 23 or 24 pins and by day 29 or 30 harvest first flush.
Anthony Diaz –
These are extremely aggressive and make blankets
shookonespt22003 –
Biggest producer I’ve ever seen. Good looking quality and healthy
iantplattner –
ITW Best online Vender great genetics you can go straight to grain honestly – Thanks ITW
Barbara Lyon –
another fantastic iso from itw… working our way through the itw iso collection. literally every addition we add are top tier quality. of course its still a lot of fun to do MS pheno hunts. these iso options can really help the beginner learn a lot about the craft, while skirting a lot of the cons MS can bring. Or not having to clean up on agar 1st.
Elite level cuts…
dvdjordan4 –
Order arrived on time and was as described and more. Could not be happier with results. Only can sayThanks ITW.
Tanner Littrell –
Very fast colonizer but potency is always a hit or miss with these.
mongiello28 –
Fastest colonizer I have ever seen… a 24hr Timelapse is mindblowing!
rachelwatsky –
Really great strain for a beginner! I inoculated with Hillbilly a week after a few other liquid cultures and this one was fully harvested before the others even entered fruiting conditions.
Robert Payne –
Great for beginners! Most aggressive iso I’ve seen! Thanks Drew for offering this one. I had a lot of failures in the beginning, until I got this iso.
benjaminwwest0 –
Great stuff extremely fast rhizomorphic growth, first buying from ITW and i will be coming back here regularly.
chris57k14 –
WoW is all I have to say. I will honestly never buy from another vendor ITW is literally IT.
rachelwatsky –
Super easy and fast growing, outpaced other varieties that I had started much earlier. Great for noobs.
karl747 –
Super fast colonizer…amazing first 24 hours!
James Betenbough –
Super fast shipping. Discrete and well packaged. Only thing missing is a cool ITW sticker!
Lonnie Gosha –
POTENT !
Lorana Rush –
Simple process. Happy!
mitchell.j.plank –
Happy with product!
ilya bogdanovskiy –
crazy genetics. fastest i’ve seen from any strain, love ITW, always high quality
Bryant Payton –
Started the race one week after 3 different opponents and still finished it 1 week before them. Very happy
smiramontes83 –
amazing
jimmywong22cal –
Thickest syringe I’ve ever recorded!!!
alsenoh –
Fast
TripAP –
Syringe was absolutely stuffed. ITW is the best
jeffrey treesh –
Very aggressive, good strain for beginners
mmee272021 –
Love me some hillbilly. Always fast.